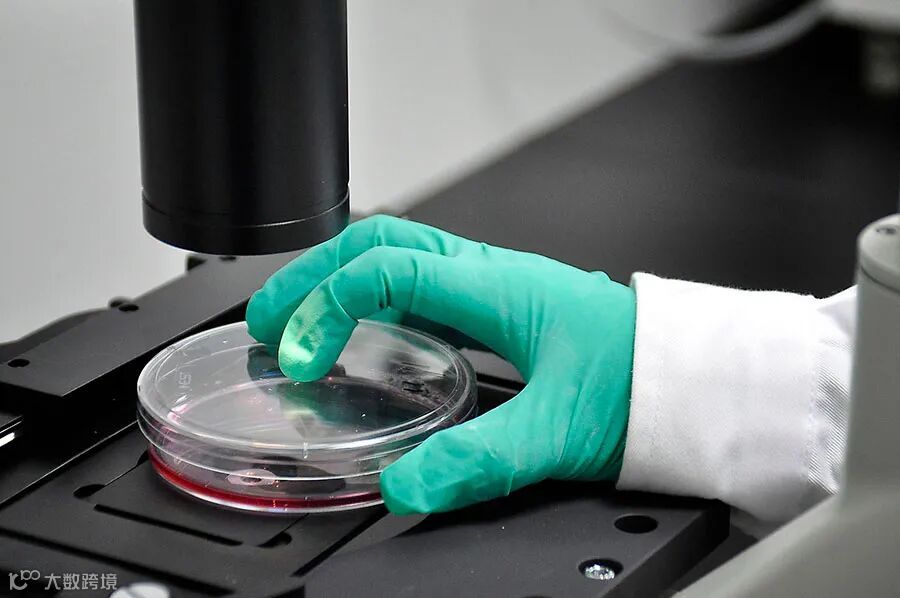

为大力实施重庆英才集聚工程,切实加强高层次青年科技人才队伍建设,充分激发科技人才创新活力,加快建设具有全国影响力的科技创新中心,重庆市科技局近日印发《重庆市博士“直通车”科研项目实施细则(试行)》(以下简称“实施细则”)。《实施细则》共12条,自2021年7月1日起试行,包括制订依据和目的,项目类别、实施周期、资助强度和申报资格,项目组织实施流程和管理方式。
据介绍,市科技局将在市级科技计划体系中细化设立重庆市博士“直通车”科研项目(以下简称博士项目),以壮大重庆英才队伍为目标,鼓励和支持来(留)渝博士深耕专业领域,发挥示范和引领作用,推动用人单位更好地引进高层次科技人才。

《实施细则》明确,博士项目分为基础研究项目和技术创新项目两类,实施周期不超过2年,资助额度为10万元/项。
基础研究项目
以培养“重庆英才·科技创新领军人才”为目标,支持来(留)渝博士瞄准专业领域的科技前沿和围绕全市经济社会发展中的前沿关键科学技术问题,开展原始创新和自由探索。
技术创新项目
以培养“重庆英才•科技创新领军人才”和“重庆英才•创新创业示范团队”为目标,支持来(留)渝博士对接市场需求和围绕战略性新兴产业发展需要,研究开发具有创新性、成熟度、稳定性、可靠性的新技术、新产品和关键部件。
《实施细则》指出
申请和实施博士项目
不纳入市级科技计划限项管理范围
符合条件的博士均可申请1项
在适用对象方面,申请博士项目支持的
应同时符合下列条件:
《实施细则》规定,对博士项目实行自主选题、审核立项、自主管理、自主结题的方式组织实施。具体程序包括项目征集、申报、公示、立项、结题等。市科技局将于每年10月底前发布征集博士项目的通知,符合条件的博士可在规定的时限内登陆“重庆市科研项目系统——博士直通车项目”在线填写和提交项目申报书。市科技局将根据专家组建议意见,确定拟立项的项目名单。经公示无异议的博士项目(含不宜公示的博士项目),市科技局于翌年4月底前下达立项计划并一次性拨付项目经费。

在项目实施方面,博士项目自立项计划下达之日起开始实施。用人单位需根据本单位科研管理规章制度进行过程管理。项目结题方面,博士项目在实施周期内完成目标任务后,项目负责人申请用人单位组织验收。通过验收的,由项目负责人在线填写结题信息并上传项目重点环节的研发记录和用人单位同意结题的书面意见。每年6月和12月,市科技局将集中公布博士项目结题名单。
在北京理工大学重庆创新中心现代兵器实验室,黄广炎(左)教授正带着博士研究生进行防爆材料配方调试。图 | 重庆日报 张锦辉/视觉重庆
值得注意的是,《实施细则》还明确,博士项目将遵循科研活动规律和落实“放管服”改革要求,着力激发科技人才创新活力。如赋予科研人员自主权。具体来说,《实施细则》提出项目负责人可在目标任务不变、项目绩效可靠、研发记录完备的前提下,自行调整研究方法、技术路线和项目组成员。项目经费可包干使用,支出不设科目与比例限制,根据研发活动据实开支,由项目负责人签字报销。
同时,强化用人单位的项目管理主体责任。《实施细则》提出,用人单位须对项目加强过程管理,对经费进行单独核算;项目实施周期内,博士从原用人单位离职仍在渝工作的,应在2个月内向原用人单位申请划转项目经费。原用人单位应将剩余研究经费及时划转至新用人单位,并报市科技局备案。项目结题验收由市科技局组织;博士从原用人单位离职且在2个月内未申请划转项目经费的,项目自行终止。剩余研究经费按原渠道退回。

市科技局相关负责人介绍,博士项目将实行以信任为前提的科研管理机制。申报和实施博士项目,博士及其用人单位需坚持诚实守信原则。博士项目结题后,市科技局可采取“双随机一公开”的方式,抽查部分项目进行绩效评价。对经举报查实存在重复申报、弄虚作假等行为或绩效评价结果较差的,博士及用人单位将纳入科研失信行为管理;情节严重的,将与其他社会领域信用信息共享,实施联合惩戒。
此外,《实施细则》明确,博士项目经费的包干使用和管理情况将接受科技、财政、审计等部门的检查和监督。对检查中发现的违法行为,按照《财政违法行为处罚处分条例》等有关规定予以处理。
查看《实施细则》全文或政策解读
请点击左下角“阅读原文”
进入重庆市科技局官网了解


│大家都爱读│




